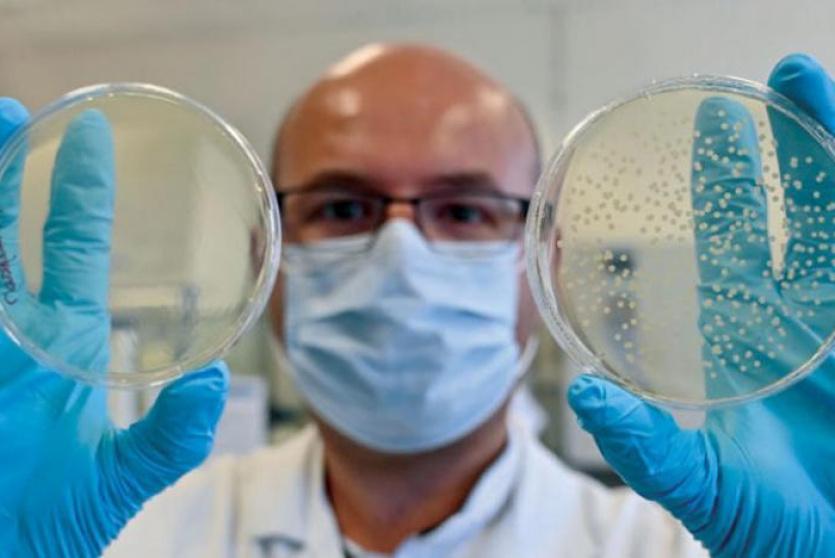
فيروس كورونا

كوفيد-19: سؤال وجواب
أصدر منظمة الصحة العالمية، إرشاد وتعليمات تساعد على الحد من تفشي جائحة كورونا حول العالم، تحت عنوان "مرض فيروس كورونا (كوفيد-19)" سؤال وجواب، وتوضح فيها كيفية انتشار الفيروس وكيف يؤثر على الناس حول العالم.
ما هو فيروس كورونا؟
فيروسات كورونا هي سلالة واسعة من الفيروسات التي قد تسبب المرض للحيوان والإنسان. ومن المعروف أن عدداً من فيروسات كورونا تسبب لدى البشر أمراض تنفسية تتراوح حدتها من نزلات البرد الشائعة إلى الأمراض الأشد وخامة مثل متلازمة الشرق الأوسط التنفسية (ميرس) والمتلازمة التنفسية الحادة الوخيمة (سارس). ويسبب فيروس كورونا المُكتشف مؤخراً مرض كوفيد-19.
ما هو مرض كوفيد-19؟
مرض كوفيد-19 هو مرض معد يسببه آخر فيروس تم اكتشافه من سلالة فيروسات كورونا. ولم يكن هناك أي علم بوجود هذا الفيروس الجديد ومرضه قبل بدء تفشيه في مدينة ووهان الصينية في كانون الأول/ ديسمبر 2019. وقد تحوّل كوفيد-19 الآن إلى جائحة تؤثر على العديد من بلدان العالم.
ما هي أعراض مرض كوفيد-19؟
تتمثل الأعراض الأكثر شيوعاً لمرض كوفيد-19 في الحمى والإرهاق والسعال الجاف. وتشمل الأعراض الأخرى الأقل شيوعاً ولكن قد يُصاب بها بعض المرضى: الآلام والأوجاع، واحتقان الأنف، والصداع، والتهاب الملتحمة، وألم الحلق، والإسهال، وفقدان حاسة الذوق أو الشم، وظهور طفح جلدي أو تغير لون أصابع اليدين أو القدمين. وعادة ما تكون هذه الأعراض خفيفة وتبدأ بشكل تدريجي. ويصاب بعض الناس بالعدوى دون أن يشعروا إلا بأعراض خفيفة جداً.
ويتعافى معظم الناس (نحو 80%) من المرض دون الحاجة إلى علاج خاص. ولكن الأعراض تشتد لدى شخص واحد تقريباً من بين كل 5 أشخاص مصابين بمرض كوفيد-19 فيعاني من صعوبة في التنفس. وتزداد مخاطر الإصابة بمضاعفات وخيمة بين المسنين والأشخاص المصابين بمشاكل صحية أخرى مثل ارتفاع ضغط الدم أو أمراض القلب والرئة أو السكري أو السرطان. وينبغي لجميع الأشخاص، أيا كانت أعمارهم، التماس العناية الطبية فوراً إذا أصيبوا بالحمى و/أو السعال المصحوبين بصعوبة في التنفس/ضيق النفس وألم أو ضغط في الصدر أو فقدان القدرة على النطق أو الحركة. ويوصى، قدر الإمكان، بالاتصال بالطبيب أو بمرفق الرعاية الصحية مسبقاً، ليتسنى توجيه المريض إلى العيادة المناسبة.
ماذا أفعل إذا كنت مصاباً بأعراض كوفيد-19 ومتى ينبغي أن التمس الرعاية الطبية؟
إذا كانت أعراضك خفيفة، من قبيل الكحة البسيطة أو الحمى الطفيفة، فلا حاجة عموماً إلى طلب الرعاية الطبية. الزم المنزل واعزل نفسك وراقب أعراضك. واتبع الإرشادات الوطنية عن العزل الذاتي. ولكن إذا كنت تعيش في منطقة تنتشر فيها الملاريا أو حمى الضنك، فمن الضروري ألا تتجاهل أعراض الحمى. اطلب المساعدة الطبية. وعندما تتوجه إلى مرفق الرعاية الصحية ضع كمامة إن أمكن، وحافظ على مسافة متر واحد على الأقل بينك وبين الآخرين وتجنب لمس الأسطح المحيطة بيديك. وإذا كان المريض طفلاً، فساعده على الالتزام بهذه النصائح.

التمس الرعاية الطبية على الفور إذا كنت تشعر بصعوبة في التنفس أو بألم/ضغط في الصدر. اتصل بالطبيب مسبقاً، إن أمكن، ليتسنى له إرشادك إلى المرفق الصحي المناسب.
كيف ينتشر مرض كوفيد-19؟
يمكن أن يلقط الأشخاص عدوى كوفيد-19 من أشخاص آخرين مصابين بالفيروس. وينتشر المرض بشكل أساسي من شخص إلى شخص عن طريق القُطيرات الصغيرة التي يفرزها الشخص المصاب بكوفيد-19 من أنفه أو فمه عندما يسعل أو يعطس أو يتكلم. وهذه القطيرات وزنها ثقيل نسبياً، فهي لا تنتقل إلى مكان بعيد وإنما تسقط سريعاً على الأرض. ويمكن أن يلقط الأشخاص مرض كوفيد-19 إذا تنفسوا هذه القُطيرات من شخص مصاب بعدوى الفيروس. لذلك من المهم الحفاظ على مسافة متر واحد على الأقل (3 أقدام) من الآخرين. وقد تحط هذه القطيرات على الأشياء والأسطح المحيطة بالشخص، مثل الطاولات ومقابض الأبواب ودرابزين السلالم. ويمكن حينها أن يصاب الناس بالعدوى عند ملامستهم هذه الأشياء أو الأسطح ثم لمس أعينهم أو أنفهم أو فمهم. لذلك من المهم المواظبة على غسل اليدين بالماء والصابون أو تنظيفهما بمطهر كحولي لفرك اليدين.
وتعكف المنظمة على تقييم البحوث الجارية حول طرق انتشار مرض كوفيد-19 وستواصل نشر أحدث ما تتوصل إليه هذه البحوث من نتائج.
هل يمكن التقاط عدوى كوفيد-19 من شخص لا تظهر عليه أعراض المرض؟
تنتشر عدوى كوفيد-19 أساساً عن طريق القطيرات التنفسية التي يفرزها شخص يسعل أو لديه أعراض أخرى مثل الحمى أو التعب. ولكن العديد من الأشخاص المصابين بعدوى كوفيد-19 لا تظهر عليهم سوى أعراض خفيفة جداً. وينطبق ذلك بشكل خاص في المراحل الأولى من المرض. ويمكن بالفعل التقاط العدوى من شخص يعاني من سعال خفيف ولا يشعر بالمرض.
وتشير بعض التقارير إلى أن الفيروس يمكن أن ينتقل حتى من الأشخاص الذين لا تظهر عليهم أي أعراض. وليس معروفاً حتى الآن مدى انتقال العدوى بهذه الطريقة. وتواصل المنظمة تقييم البحوث الجارية في هذا الصدد وستواصل نشر أي نتائج محدّثة بهذا الشأن.
كيف يمكن لنا حماية الآخرين وحماية أنفسنا من العدوى إذا لم نكن نعلم من مصاب بها؟
إن الحرص على ممارسة نظافة اليدين والجهاز التنفسي مهمة في جميع الأوقات وهي أفضل طريقة لحماية نفسك والآخرين.
حافظ على مسافة متر واحد على الأقل (3 أقدام) بينك وبين الآخرين عند الإمكان. وهي مسألة مهمة بشكل خاص إذا كنت تقف قرب شخص يسعل أو يعطس. وبما أن بعض الأشخاص المصابين بالعدوى قد لا تظهر عليهم الأعراض بعد أو لديهم أعراض خفيفة فقط، فإن الحفاظ على مسافة متباعدة عن الجميع هو فكرة جيدة إذا كنت في منطقة يسري فيها مرض كوفيد-19.
ماذا أفعل إذا كنت قد خالطت عن قربٍ شخصاً مصاباً بكوفيد-19؟
إذا كنت قد خالطت عن قربٍ شخصاً مصاباً بكوفيد-19 فقد تكون العدوى قد انتقلت إليك أيضاً.
والمخالطة القريبة تعني أنك تعيش مع شخص مصاب بالمرض أو كنت معه في نفس المكان على مسافة تقل عن متر واحد (3 أقدام).
ولكن إذا كنت تعيش في منطقة تنتشر فيها الملاريا أو حمى الضنك، فمن الضروري ألا تتجاهل أعراض الحمى. اطلب المساعدة الطبية. وعندما تتوجه إلى مرفق الرعاية الصحية ضع كمامة إن أمكن، وحافظ على مسافة متر واحد على الأقل بينك وبين الآخرين وتجنب لمس الأسطح المحيطة بيديك. وإذا كان المريض طفلاً، فساعده على الالتزام بهذه النصائح.
أما إذا كنت لا تعيش في منطقة تنتشر فيها الملاريا أو حمى الضنك، فالرجاء اتباع النصائح التالية:
إذا شعرت بالتوعك، ولو بأعراض خفيفة جداً مثل الحمى الخفيفة أو الأوجاع، فعليك أن تعزل نفسك بالبقاء في المنزل.
حتى إذا اعتقدت أنك لم تتعرض للإصابة بعدوى كوفيد-19 ولكن ظهرت عليك هذه الأعراض فاعزل نفسك وراقب أعراضك.
تزداد احتمالات انتقال العدوى في المراحل الأولى من المرض عندما تكون الأعراض خفيفة، لذلك من المهم جداً أن تعزل نفسك مبكراً.
إذا لم تظهر عليك أي أعراض ولكنك خالطت شخصاً مصاباً بالعدوى، فالزم الحجر الصحي لمدة 14 يوماً.
إذا تأكدت (بالفحص المختبري) إصابتك بعدوى كوفيد-19، فعليك أن تعزل نفسك لمدة 14 يوماً حتى بعد تلاشي الأعراض، كإجراء احتياطي. فليس معروفاً على وجه الدقة حتى الآن المدة التي يظل فيها الشخص معدياً بعد تعافيه من المرض. اتبع الإرشادات الوطنية بشأن العزل الذاتي.
ما الذي يعنيه العزل الذاتي؟
العزل الذاتي إجراء مهم يطبقه الأشخاص الذين تظهر عليهم أعراض كوفيد-19 لتجنب نقل العدوى للآخرين في المجتمع، بمن في ذلك أفراد عائلتهم.
والمقصود بالعزل الذاتي هو عندما يلزم الشخص المصاب بالحمى أو السعال أو غير ذلك من أعراض مرض كوفيد-19، بيته ويمتنع عن الذهاب إلى العمل أو المدرسة أو الأماكن العامة. وهذا العزل يمكن أن يحدث بشكل طوعي أو يستند إلى توصية من مقدم الرعاية الصحية. ولكن إذا كنت تعيش في منطقة تنتشر فيها الملاريا أو حمى الضنك، فمن الضروري ألا تتجاهل أعراض الحمى. اطلب المساعدة الطبية. وعندما تتوجه إلى مرفق الرعاية الصحية ضع كمامة إن أمكن، وحافظ على مسافة متر واحد على الأقل بينك وبين الآخرين وتجنب لمس الأسطح المحيطة بيديك. وإذا كان المريض طفلاً، فساعده على الالتزام بهذه النصائح.
أما إذا كنت لا تعيش في منطقة تنتشر فيها الملاريا أو حمى الضنك، فالرجاء اتباع النصائح التالية:
- إذا كان شخص ما في العزل الذاتي، فالسبب هو أنه يشعر بالتوعك دون أن يكون مرضه شديداً (أي لا يستدعي العناية الطبية)
اختر للعزل غرفة منفصلة واسعة وجيدة التهوية مزودة بمرحاض ولوازم تنظيف اليدين.
إذا لم تتوفر غرفة منفصلة فباعد بين أسرّة النوم مسافة متر واحد على الأقل.
حافظ على مسافة متر واحد على الأقل من الآخرين، بمن في ذلك أفراد أسرتك.
راقب أعراضك بشكل يومي.
اعزل نفسك 14 يوماً حتى لو شعرت أنك بصحة جيدة.
إذا ظهرت لديك أعراض الصعوبة في التنفس فاستشر طبيبك على الفور، واتصل هاتفياً أولاً إن أمكن.
حافظ على إيجابيتك وحيويتك بالبقاء على اتصال مع أحبتك بالهاتف أو عبر الإنترنت، أو بممارسة بعض التمارين الرياضية في المنزل.
ماذا أفعل إن لم تكن لدي أعراض ولكني أعتقد أني قد تعرّضت لعدوى كوفيد-19؟ ما الذي يعنيه الحجر الصحي الذاتي؟
الحجر الصحي الذاتي هو أن تعزل نفسك عن الآخرين لأنك خالطت شخصاً مصاباً بمرض كوفيد-19، رغم عدم ظهور أي أعراض عليك. وينبغي أن تراقب نفسك لرصد أي أعراض قد تظهر عليك أثناء الحجر الصحي. والهدف من الحجر الصحي الذاتي هو منع انتقال العدوى. فالأشخاص الذين يصابون بمرض كوفيد-19 يمكنهم نقل العدوى إلى الآخرين فوراً، لذلك من شأن الحجر الصحي أن يمنع انتقال العدوى.
وفي حالة الحجر الصحي:
اختر غرفة منفصلة واسعة وجيدة التهوية مزودة بمرحاض ولوازم تنظيف اليدين.
إذا لم تتوفر غرفة منفصلة فباعد بين أسرّة النوم مسافة متر واحد على الأقل.
حافظ على مسافة متر واحد على الأقل من الآخرين، بمن في ذلك أفراد أسرتك.
راقب أعراضك بشكل يومي.
امكث في الحجر الصحي الذاتي 14 يوماً حتى لو شعرت أنك بصحة جيدة.
إذا ظهرت لديك أعراض الصعوبة في التنفس فاستشر طبيبك على الفور، واتصل هاتفياً أولاً إن أمكن.
حافظ على إيجابيتك وحيويتك بالبقاء على اتصال مع أحبتك بالهاتف أو عبر الإنترنت، أو بممارسة بعض التمارين الرياضية في المنزل.
ولكن إذا كنت تعيش في منطقة تنتشر فيها الملاريا أو حمى الضنك، فمن الضروري ألا تتجاهل أعراض الحمى. اطلب المساعدة الطبية. وعندما تتوجه إلى مرفق الرعاية الصحية ضع كمامة إن أمكن، وحافظ على مسافة متر واحد على الأقل بينك وبين الآخرين وتجنب لمس الأسطح المحيطة بيديك. وإذا كان المريض طفلاً، فساعده على الالتزام بهذه النصائح.
ما هو الفرق بين العزل الذاتي والحجر الصحي الذاتي والتباعد الجسدي؟
الحجر الصحي يعني تقييد الأنشطة وعزل الأشخاص غير المرضى هم أنفسهم ولكنهم ربما تعرّضوا للإصابة بعدوى كوفيد-19. والهدف هو منع انتشار المرض في الوقت الذي لا تكاد تظهر أي أعراض على الشخص.
أما العزل فيعني عزل الأشخاص المرضى الذين تظهر عليهم أعراض كوفيد-19 ويمكنهم نقل عدواه، لمنع انتشار المرض.
ويعني التباعد الجسدي الابتعاد عن الآخرين جسدياً. وتوصي المنظمة بالابتعاد عن الآخرين مسافة متر واحد (3 أقدام) على الأقل. وهي توصية عامة يتعين على الجميع تطبيقها حتى لو كانوا بصحة جيدة ولم يتعرضوا لعدوى كوفيد-19.
هل يمكن أن يُصاب الأطفال والمراهقون بمرض كوفيد-19؟
تشير البحوث إلى أن احتمالات إصابة الأطفال والمراهقين بعدوى كوفيد-19 وإمكانية نشرهم للعدوى لا تختلف عن الفئات العمرية الأخرى.
وتشير الأدلة المتاحة حتى اليوم إلى أن الأطفال واليافعين أقل عرضة للإصابة بمضاعفات المرض الوخيمة، ولكن لا يزال حدوث ذلك ممكناً وسط هذه الفئة العمرية.
وينبغي أن يتبع الأطفال والمراهقون نفس الإرشادات عن الحجر الصحي الذاتي والعزل الذاتي إذا تعرضوا لخطر الإصابة بالعدوى أو إذا ظهرت عليهم أعراضها. ومن المهم بشكل خاص أن يتجنب الأطفال مخالطة كبار السن والآخرين الأكثر عرضة للإصابة بمضاعفات المرض الوخيمة.
يمكنك الحد من احتمالات إصابتك بعدوى كوفيد-19 أو نشرها باتخاذ بعض الاحتياطات البسيطة:
واظب على تنظيف يديك جيداً بفركهما بمطهر كحولي لليدين أو بغسلهما بالماء والصابون.
لماذا؟ إن تنظيف يديك بالماء والصابون أو فركهما بمطهر كحولي يقتل الفيروسات التي قد تكون على يديك.
حافظ على مسافة متر واحد (3 أقدام) على الأقل بينك وبين الآخرين.
لماذا؟ عندما يسعل شخص أو يعطس، فإنه يفرز من أنفه أو فمه قُطيرات سائلة صغيرة قد تحتوي على الفيروس. فإذا كنت قريباً جداً منه يمكن أن تتنفس هذه القُطيرات، بما في ذلك الفيروس المسبب لمرض كوفيد-19 إذا كان ذلك الشخص مصاباً به.
تجنب الأماكن المزدحمة
لماذا؟ عندما يحتشد الناس في أماكن مكتظة تزداد احتمالات مخالطة شخص مصاب بمرض كوفيد-19 ويصعب الحفاظ على مسافة متر واحد (3 أقدام) بينك وبين الآخرين.
تجنب لمس عينيك وأنفك وفمك.
لماذا؟ تلامس اليدان العديد من الأسطح ويمكنهما التقاط الفيروسات. وإذا تلوثت اليدان فإنهما قد تنقلان الفيروس إلى العينين أو الأنف أو الفم. ومن هذه المنافذ يمكن للفيروس أن يدخل إلى جسمك ويصيبك بالمرض
تأكد من اتّباعك أنت والمحيطين بك ممارسات النظافة التنفسية الجيدة. ويعني ذلك أن تغطي فمك وأنفك بثني المرفق أو بمنديل ورقي عند السعال أو العطس. تخلص من المنديل بعد استعماله فوراً.
لماذا؟ القُطيرات تنشر الفيروس. وباتّباع ممارسات النظافة التنفسية الجيدة تحمي الأشخاص من حولك من الفيروسات المسببة لأمراض مثل الرشح والأنفلونزا وكوفيد-19.
إلزم المنزل واعزل نفسك حتى لو كانت لديك أعراض خفيفة مثل السعال والصداع والحمى الخفيفة، إلى أن تتعافى. اطلب من شخص آخر أن يحضر لك مشترياتك. وإذا اضطررت إلى مغادرة المنزل، ضع كمامة لتجنب نقل العدوى إلى الآخرين.
لماذا؟ تجنب مخالطة الآخرين يحميهم من إمكانية الإصابة بعدوى كوفيد-19 وغيره من الفيروسات.
إذا كنت مصاباً بالحمى والسعال وصعوبة التنفس، التمس الرعاية الطبية واتصل بمقدم الرعاية إن أمكن قبل التوجه إليه، واتّبع توجيهات السلطات الصحية المحلية.
كيف أتجنب الإصابة بعدوى فيروس كورونا (كوفيد-19) عندما أحيي الآخرين؟
للوقاية من كوفيد-19، تفادى أي ملامسة جسدية عندما تحيي الآخرين. وتشمل التحيات المأمونة التلويح والإيماء والانحناء.
هل هناك لقاح أو دواء أو علاج لمرض كوفيد-2019؟
في حين قد تريح بعض العلاجات الغربية أو التقليدية أو المنزلية من بعض أعراض كوفيد-19 أو تخففها، فلا توجد حالياً أدوية ثبت أن من شأنها الوقاية من هذا المرض أو علاجه. ولا توصي المنظمة بالتطبيب الذاتي بأي أدوية، بما في ذلك المضادات الحيوية، سواء على سبيل الوقاية من مرض كوفيد-19 أو معالجته. غير أن هناك عدة تجارب سريرية جارية تتضمن أدوية غربية وتقليدية معاً. وتتولى المنظمة تنسيق الجهود الرامية إلى تطوير لقاحات وأدوية للوقاية من مرض كوفيد-19 وعلاجه، وستواصل إتاحة معلومات محدّثة بهذا الشأن حالما تتوفر نتائج هذه الأبحاث.
هل توصي منظمة الصحة العالمية بارتداء كمامات طبية لتجنب نشر عدوى كوفيد-19؟
لا توجد أدلة حالياً تؤيد أو تنفي جدوى ارتداء الكمامات (الطبية أو غيرها) من الأشخاص الأصحاء في المجتمع عموماً. غير أن المنظمة تعكف على دراسة المعارف العلمية السريعة التطور بشأن الكمامات وتحدّث إرشاداتها في هذا الشأن بشكل مستمر.
يوصى بارتداء الكمامات الطبية أساساً في مرافق الرعاية الصحية، ولكن يمكن النظر في استخدامها في ظروف أخرى أيضا (انظر أدناه). وينبغي أن يقترن استخدام الكمامات الطبية بالتدابير الرئيسية الأخرى للوقاية من العدوى ومكافحتها، مثل نظافة اليدين والتباعد الجسدي.
العاملون في المجال الصحي
لماذا؟ يوصى باستخدام الكمامات الطبية وأقنعة التنفس من نوعي N95 وFFP وما يكافئهما، للعاملين في مجال الرعاية الصحية حصراً أثناء تقديم الرعاية للمرضى. فالمخالطة اللصيقة لأشخاص مصابين بعدوى كوفيد-19 المؤكدة أو المشتبه فيها وملامسة البيئة المحيطة بهم هي الطرق الرئيسية لانتقال العدوى، مما يعني أن العاملين في مجال الرعاية الصحية هم الأكثر عرضةً للإصابة بالعدوى.
المرضى الذين تظهر عليهم أعراض كوفيد-19
لماذا؟ أي شخص مريض تظهر عليه أعراض خفيفة مثل الأوجاع العضلية أو السعال الخفيف أو احتقان الحلق أو التعب، ينبغي أن يعزل نفسه في المنزل ويضع كمامة طبية وفقاً لتوصيات المنظمة بشأن الرعاية المنزلية للمرضى المشتبه في إصابتهم بعدوى كوفيد-19. والقطيرات التي يفرزها الشخص عندما يسعل أو يعطس أو يتكلم يمكن أن تنشر العدوى. وقد تصل هذه القطيرات إلى وجوه الآخرين القريبين من المريض أو تحط على أسطح البيئة المحيطة به. وإذا عطس الشخص المصاب بالعدوى أو سعل أو تكلم وهو يرتدي كمامة طبية فبإمكان ذلك أن يحمي الأشخاص القريبين منه من الإصابة بالعدوى.
وكذلك إذا اضطر شخص مريض للذهاب إلى مرفق للرعاية الصحية فعليه أن يضع كمامة طبية.
كل شخص يقدم الرعاية المنزلية لمريض مصاب بكوفيد-19
لماذا؟ ينبغي أن يرتدي القائمون على رعاية مرضى كوفيد-19 كمامة طبية لحماية أنفسهم. فالمخالطة القريبة والمتكررة ولفترة طويلة مع شخص مصاب بكوفيد-19 يجعل مقدم الرعاية أكثر عرضةً لخطر الإصابة بالعدوى.
وقد يختار صانعو القرار على المستوى الوطني التوصية باستخدام الكمامات الطبية لأفراد معينين استناداً إلى نهج قائم على المخاطر. ويراعي هذا النهج الغرض من استخدام الكمامة ومستوى مخاطر التعرّض وشدتها والظرف وجدوى الاستخدام وأنواع الكمامات الممكن استخدامها.
كيف ترتدي الكمامة على النحو الصحيح
إذا قررت أن ترتدي كمامة فاتبع الإرشادات التالية:
1. قبل لمس الكمامة، نظف يديك بفركهما بمطهر كحولي أو بغسلهما بالماء والصابون.
2. تفقد الكمامة وتأكد من خلوها من الشقوق والثقوب.
3.حدد الطرف العلوي من الكمامة (موضع الشريط المعدني).
4. تأكد من توجيه الجهة الصحيحة من الكمامة إلى الخارج (الجهة الملونة).
5. ضع الكمامة على وجهك. اضغط على الشريط المعدني أو الطرف المقوى للكمامة ليتخذ شكل أنفك.
6. اسحب الجزء السفلي من الكمامة لتغطي فمك وذقنك.
7.لا تلمس الكمامة ما دمت ترتديها للحماية.
8.بعد الاستخدام، اخلع الكمامة بنزع الشريط المطاطي من خلف الأذنين مع الحرص على إبعادها عن وجهك وملابسك لتجنب ملامسة أجزاء الكمامة التي يحتمل أن تكون ملوثة.
9.تخلص من الكمامة المستعملة على الفور برميها في سلة مهملات مغلقة. لا تستخدم الكمامة المستعملة مرة أخرى.
10.نظف يديك بعد ملامسة الكمامة أو رميها، إما بفركهما بمطهر كحولي أو بغسلهما بالماء والصابون إذا كانتا متسختين بوضوح.
ضع في اعتبارك أن هناك نقص عالمي في الكمامات الطبية (الجراحية والكمامات من نوع N95) لذلك ينبغي الاحتفاظ بهذه الكمامات لاستخدام العاملين في مجال الرعاية الصحية حصراً، قدر الإمكان.
وتذكّر أن استخدام الكمامة ليس بديلاً عن الطرق الأخرى الأكثر فعالية لحماية نفسك والآخرين من عدوى كوفيد-19، مثل المواظبة على غسل اليدين وتغطية الفم والأنف بثني المرفق أو بمنديل ورقي عند السعال، والحفاظ على مسافة متر واحد (3 أقدام) على الأقل بينك وبين الآخرين. انظر تدابير الحماية الأساسية من فيروس كورونا الجديد للحصول على مزيد من المعلومات بهذا الشأن.
اتبع النصائح الصادرة عن السلطات الصحية الوطنية بشأن استخدام الكمامات.
كم من الوقت يستغرق ظهور الأعراض بعد التعرّض لعدوى كوفيد-19؟
تستغرق المدة من وقت التعرض للإصابة بكوفيد-19 إلى حين بدء ظهور الأعراض نحو خمسة إلى ستة أيام، ولكنها يمكن أن تتراوح من 1 إلى 14 يوماً.
ما هو الرابط بين مرض كوفيد-19 والحيوانات؟
ينتشر مرض كوفيد-19 عن طريق الانتقال بين البشر.
ونعرف الكثير بالفعل عن فيروسات أخرى من فصيلة فيروسات كورونا، ونعلم أن معظم هذه الأنواع من الفيروسات حيوانية المصدر. والفيروس المسبب لمرض كوفيد-19 (يُسمى أيضا فيروس كورونا-سارس-2) هو فيروس جديد في البشر. ولم يؤكد بعد المصدر الحيواني المحتمل لكوفيد-19 ولا يزال البحث مستمراً.
وتواصل المنظمة رصد آخر الأبحاث في هذا المجال وغيره من المواضيع المتعلقة بكوفيد-19 وستحدّث هذه المعلومات إذا ظهرت استنتاجات جديدة.
هل يمكن أن أُصاب بعدوى كوفيد-19 عن طريق حيوانات أليفة أو أي حيوانات أخرى؟
أظهرت الاختبارات التشخيصية نتائج إيجابية تؤكد إصابة العديد من الكلاب والقطط (القطط المنزلية والنمور) بعدوى كوفيد-19 بعد مخالطتها أشخاصاً مصابين بالعدوى. إضافة إلى ذلك، يبدو أن سنانير الزباد أيضاً معرّضة للإصابة بالعدوى. وتبيّن في ظروف مختبرية أن كلاً من القطط والزباد لديها القدرة على نقل العدوى إلى حيوانات أخرى من نفس الفصيلة. غير أنه لا توجد بيّنات تدل على قدرة هذه الحيوانات على نقل مرض كوفيد-19 إلى البشر والتسبب في انتشاره. فعدوى كوفيد-19 تنتشر بشكل رئيسي عن طريق القطيرات التي يفرزها الشخص المصاب بالعدوى عندما يسعل أو يعطس أو يتكلم.
واكتُشف الفيروس كذلك لدى النموس المدّجنة في المزارع، حيث يُرجح أنها أصيبت بالعدوى من عمال المزارع. وفي حالات قليلة، تبيّن أن النموس المصابة بالعدوى من البشر قد نقلت الفيروس إلى أشخاص آخرين. وتعدّ هذه أولى حالات يبلغ فيها عن انتقال الفيروس من الحيوان إلى الإنسان.
تُظهر نتائج التجارب المختبرية كذلك أن القطط والنموس لديها القدرة على نقل العدوى إلى حيوانات أخرى من نفس الفصيلة. ومن الممكن أن يكون بمقدور هذه الحيوانات نقل العدوى إلى البشر أيضاً. وما زلنا في طور جمع البيانات واستعراضها للتوصل إلى فهم أفضل لنطاق هذا الانتقال من الحيوان إلى الإنسان.
وما زالت المنظمة توصي الأشخاص المصابين بكوفيد-19 والأشخاص المعرّضين لخطر الإصابة به بالحدّ من مخالطة حيوانات الرفقة وغيرها من الحيوانات. وينبغي الحرص دوماً على تطبيق تدابير النظافة الأساسية عند التعامل مع الحيوانات ورعايتها. ويشمل ذلك غسل اليدين بعد التعامل مع الحيوانات أو مع طعامها أو لوازمها، فضلاً عن تجنب التقبيل أو اللعق أو الطعام المشترك.
وتواصل المنظمة رصد آخر الأبحاث في هذا المجال وفي غيره من المواضيع المتعلقة بكوفيد-19 وستحدّث هذه المعلومات إذا ظهرت نتائج جديدة.
ما هي مدة بقاء الفيروس على الأسطح المختلفة؟
أهم ما ينبغي معرفته عن بقاء فيروس كورونا على الأسطح هو أن بالإمكان تطهيرها منه بسهولة بواسطة محاليل التعقيم المنزلية العادية التي تقتل الفيروس. وقد أظهرت الدراسات أن بمقدور الفيروس المسبب لكوفيد-19 أن يبقى على البلاستيك والفولاذ المقاوم للصدأ لمدة 72 ساعة وعلى النحاس أقل من 4 ساعات وعلى الورق المقوّى (الكرتون) أقل من 24 ساعة.
كالعادة، نظف يديك جيداً عن طريق فركهما بمنظف كحولي لليدين أو غسلهما بالماء والصابون. وتجنب لمس عينيك أو فمك أو أنفك.
كيف تتسوق بصورة آمنة؟
عندما تذهب للتسوق، حافظ على مسافة متر واحد على الأقل بينك وبين الآخرين، وتجنب لمس عينيك وفمك وأنفك. قبل أن تبدأ بالتسوق، قم بتعقيم مسكة عربة أو سلة التسوق، إن أمكن. وفور عودتك إلى المنزل، اغسل يديك جيداً وكذلك بعد مناولة مشترياتك وتخزينها. ولم تُسجل حالياً أي حالات إصابة مؤكدة بكوفيد-19 انتقلت عن طريق الأطعمة أو معلباتها.
كيف تغسل الفواكه والخضروات؟
تشكّل الفواكه والخضروات مكوّناً هاماً في أي نظام غذائي صحي. وينبغي غسلها كما تفعل في الظروف العادية: قبل لمس الخضار والفواكه، اغسل يديك جيداً بالماء والصابون. ثم اغسلها جيداً بمياه نظيفة جارية، خصوصاً إذا كنت تأكلها نيئة.
هل المضادات الحيوية فعالة في الوقاية من مرض كوفيد-19 أو علاجه؟
كلا. لا تقضي المضادات الحيوية على الفيروسات، وإنما تكافح العدوى البكتيرية فقط. وبما أن مرض كوفيد-19 منشؤه فيروس، فإن المضادات الحيوية لا تنفع في مكافحته. ولا ينبغي استعمال المضادات الحيوية كوسيلة للوقاية من مرض كوفيد-19 أو علاجه. ولكن قد يصف الأطباء في المستشفى المضادات الحيوية للمرضى المصابين بمضاعفات كوفيد-19 الوخيمة لمعالجة عدوى بكتيرية ثانوية أو الوقاية منها. وينبغي التقيد بصرامة بتعليمات الطبيب لدى استعمال المضادات الحيوية لعلاج حالات العدوى البكتيرية.
هل يمكن أن أصاب بعدوى كوفيد-19 عن طريق براز شخص مصاب بالمرض؟
في حين تشير الاستقصاءات الأولية إلى احتمال وجود أثر للفيروس في البراز في بعض الحالات، فلم ترد أي تقارير عن حدوث انتقال لعدوى كوفيد-19 من البراز إلى الفم. بالإضافة إلى ذلك، لا توجد حتى الآن بيّنات على قدرة الفيروس على البقاء في الماء أو مياه الصرف الصحي.
وتعكف المنظمة على تقييم البحوث الجارية بشأن طرق انتشار مرض كوفيد-19 وستواصل نشر أي نتائج جديدة حول هذا الموضوع.


